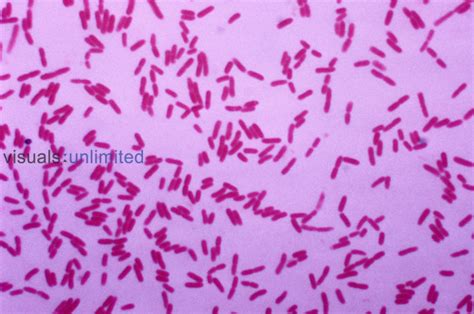

Pseudomonas Putida: Understanding The Infection
Pseudomonas Putida Infection: What You Need to Know
Hey guys! Ever heard of Pseudomonas putida ? It’s a bacterium that’s pretty common in the environment, like in soil and water. Usually, it’s not a big deal for healthy people, but sometimes it can cause infections, especially if you’ve got a weakened immune system. Let’s dive into what Pseudomonas putida is all about, how it can cause infections, and what you need to know to stay safe.
Table of Contents
What is Pseudomonas Putida?
Pseudomonas putida is a bacterium that belongs to the Pseudomonas genus. These bacteria are known for their ability to survive in various environments, including soil, water, and even the surfaces of plants. What makes Pseudomonas putida particularly interesting is its metabolic versatility. It can break down a wide range of organic compounds, which is why it’s often used in bioremediation – cleaning up pollutants in the environment. Think of it as a tiny, helpful janitor for our planet!
However, Pseudomonas putida isn’t always a good guy. While it’s generally considered less virulent than some other Pseudomonas species like Pseudomonas aeruginosa , it can still cause infections, especially in individuals with compromised immune systems. These infections are relatively rare, but it’s important to understand the risks and how to prevent them. These bacteria are rod-shaped and move around using flagella, which are like tiny propellers. They’re pretty adaptable, which is why they can survive in so many different places. Pseudomonas putida ’s ability to degrade various compounds makes it useful in industrial applications as well, such as in the production of certain chemicals. So, while you might not hear about it as often as other bacteria, Pseudomonas putida plays a significant role in both the environment and various industries. Understanding its characteristics and potential risks is key to staying informed and healthy.
How Does Pseudomonas Putida Cause Infection?
Pseudomonas putida infections typically occur when the bacteria enter the body through a break in the skin, such as a cut or wound. It can also happen through contaminated medical equipment or exposure in a hospital setting. People with weakened immune systems, such as those undergoing chemotherapy, organ transplant recipients, or individuals with HIV/AIDS, are more susceptible to these infections. So, how does this bacterium actually cause trouble?
First off, Pseudomonas putida can form biofilms, which are like sticky communities of bacteria that are hard to get rid of. These biofilms can develop on medical devices like catheters or ventilators, making it easier for the bacteria to enter the body. Once inside, Pseudomonas putida can release toxins and enzymes that damage tissues and cause inflammation. This can lead to a variety of symptoms, depending on where the infection is located. For example, if it’s a skin infection, you might see redness, swelling, and pus. If it’s a bloodstream infection, it can cause fever, chills, and even septic shock, which is a life-threatening condition. It’s important to note that while Pseudomonas putida infections are relatively rare, they can be serious, especially if they’re not treated promptly. That’s why it’s crucial to practice good hygiene, especially if you’re in a hospital or healthcare setting. Always wash your hands thoroughly, and make sure that any wounds or cuts are properly cleaned and bandaged. If you have a weakened immune system, take extra precautions to avoid exposure to bacteria, and talk to your doctor about ways to protect yourself. Remember, staying informed and proactive is the best way to stay healthy.
Symptoms of Pseudomonas Putida Infection
The symptoms of a Pseudomonas putida infection can vary depending on the site of the infection. Common symptoms include fever, chills, redness, swelling, and pain around the infected area. If the infection is in the bloodstream, it can cause more severe symptoms like low blood pressure and organ damage. Here’s a more detailed look at what you might experience:
- Skin Infections: These often appear as red, swollen, and painful areas on the skin. You might also notice pus or drainage from the wound. In some cases, a rash or blisters may develop.
- Bloodstream Infections (Bacteremia): This is a more serious condition that can cause high fever, chills, and a rapid heart rate. If left untreated, it can lead to septic shock, which is a life-threatening drop in blood pressure that can damage organs.
- Pneumonia: If Pseudomonas putida infects the lungs, it can cause pneumonia. Symptoms include coughing, chest pain, shortness of breath, and fever. The sputum (phlegm) may be greenish or yellowish.
- Urinary Tract Infections (UTIs): While less common, Pseudomonas putida can cause UTIs, leading to symptoms like frequent urination, pain or burning during urination, and cloudy or bloody urine.
- Ear Infections: These can cause ear pain, redness, swelling, and drainage from the ear canal. Hearing may also be temporarily affected.
It’s important to remember that these symptoms can also be caused by other infections or conditions. If you experience any of these symptoms and suspect you might have a Pseudomonas putida infection, it’s crucial to seek medical attention right away. Early diagnosis and treatment can help prevent serious complications. Doctors will typically perform tests to identify the specific bacteria causing the infection and determine the best course of treatment. So, stay vigilant, and don’t hesitate to get checked out if you’re concerned about any unusual symptoms.
Diagnosis and Treatment
Diagnosing a Pseudomonas putida infection typically involves culturing a sample from the infected site, such as blood, urine, or wound drainage. Once the bacteria are identified, doctors will perform antibiotic sensitivity testing to determine which antibiotics will be most effective. Treatment usually involves antibiotics, and in some cases, surgery may be necessary to remove infected tissue. So, what does the process look like?
First, your doctor will take a sample from the site of the suspected infection. This could be a blood sample, a urine sample, or a swab from a wound. The sample is then sent to a laboratory, where technicians will try to grow the bacteria in a culture. If Pseudomonas putida is present, it will multiply and form colonies that can be identified. Once the bacteria are identified, the lab will perform antibiotic sensitivity testing. This involves exposing the bacteria to different antibiotics to see which ones are most effective at killing or inhibiting their growth. The results of this testing will help your doctor choose the right antibiotic to treat your infection. Treatment for Pseudomonas putida infections typically involves a course of antibiotics, which may be given intravenously (through a vein) or orally (by mouth), depending on the severity of the infection. In some cases, surgery may be necessary to remove infected tissue, especially if the infection is severe or has formed an abscess. It’s crucial to follow your doctor’s instructions carefully and complete the full course of antibiotics, even if you start to feel better. This helps ensure that the infection is completely eradicated and prevents the bacteria from developing resistance to the antibiotics. If you have any questions or concerns about your treatment, don’t hesitate to ask your doctor. They’re there to help you get better and stay healthy!
Prevention of Pseudomonas Putida Infection
Preventing Pseudomonas putida infection involves practicing good hygiene, especially if you are in a healthcare setting or have a weakened immune system. This includes frequent hand washing, proper wound care, and avoiding contact with contaminated surfaces. Here are some practical tips to help you stay safe:
- Wash Your Hands Regularly: This is the most effective way to prevent the spread of bacteria. Wash your hands with soap and water for at least 20 seconds, especially after using the restroom, before eating, and after touching surfaces in public places.
- Practice Proper Wound Care: If you have a cut, scrape, or wound, clean it thoroughly with soap and water. Apply an antiseptic ointment and cover it with a clean bandage. Change the bandage regularly until the wound is healed.
- Avoid Sharing Personal Items: Don’t share towels, razors, or other personal items, as these can harbor bacteria.
- Be Cautious in Healthcare Settings: If you’re in a hospital or clinic, be mindful of the surfaces you touch. Use hand sanitizer frequently, and avoid touching your face.
- Keep Medical Equipment Clean: If you use medical equipment like catheters or ventilators, make sure they are properly cleaned and sterilized according to the manufacturer’s instructions.
- Strengthen Your Immune System: A healthy immune system is better able to fight off infections. Eat a balanced diet, get enough sleep, exercise regularly, and manage stress.
For those with weakened immune systems, it’s especially important to take extra precautions to avoid exposure to bacteria. Talk to your doctor about ways to boost your immune system and reduce your risk of infection. This might include getting vaccinated against certain diseases, taking prophylactic antibiotics, or following specific hygiene protocols. Remember, prevention is always better than cure. By taking these simple steps, you can significantly reduce your risk of Pseudomonas putida infection and stay healthy.
Who is at Risk?
Certain groups of people are more susceptible to Pseudomonas putida infections. These include:
- Individuals with Weakened Immune Systems: People undergoing chemotherapy, organ transplant recipients, and those with HIV/AIDS are at higher risk.
- Hospitalized Patients: Patients in hospitals, especially those in intensive care units, are more likely to be exposed to Pseudomonas putida .
- People with Chronic Diseases: Individuals with diabetes, cystic fibrosis, or other chronic conditions may have a higher risk of infection.
- Those with Burns or Wounds: Breaks in the skin provide an entry point for bacteria.
Understanding your risk factors is crucial for taking proactive steps to protect yourself. If you fall into one of these categories, it’s even more important to practice good hygiene and follow the preventive measures outlined earlier. Talk to your doctor about any concerns you have and ask about ways to minimize your risk of infection. They can provide personalized advice based on your individual health status and circumstances. Remember, being informed and proactive is the best way to stay healthy and safe.
Conclusion
So, there you have it! Pseudomonas putida infections are relatively rare but can be serious, especially for those with weakened immune systems. By understanding how these infections occur, recognizing the symptoms, and taking preventive measures, you can protect yourself and stay healthy. Always remember to practice good hygiene, especially in healthcare settings, and seek medical attention if you suspect an infection. Stay informed, stay vigilant, and stay healthy, guys!